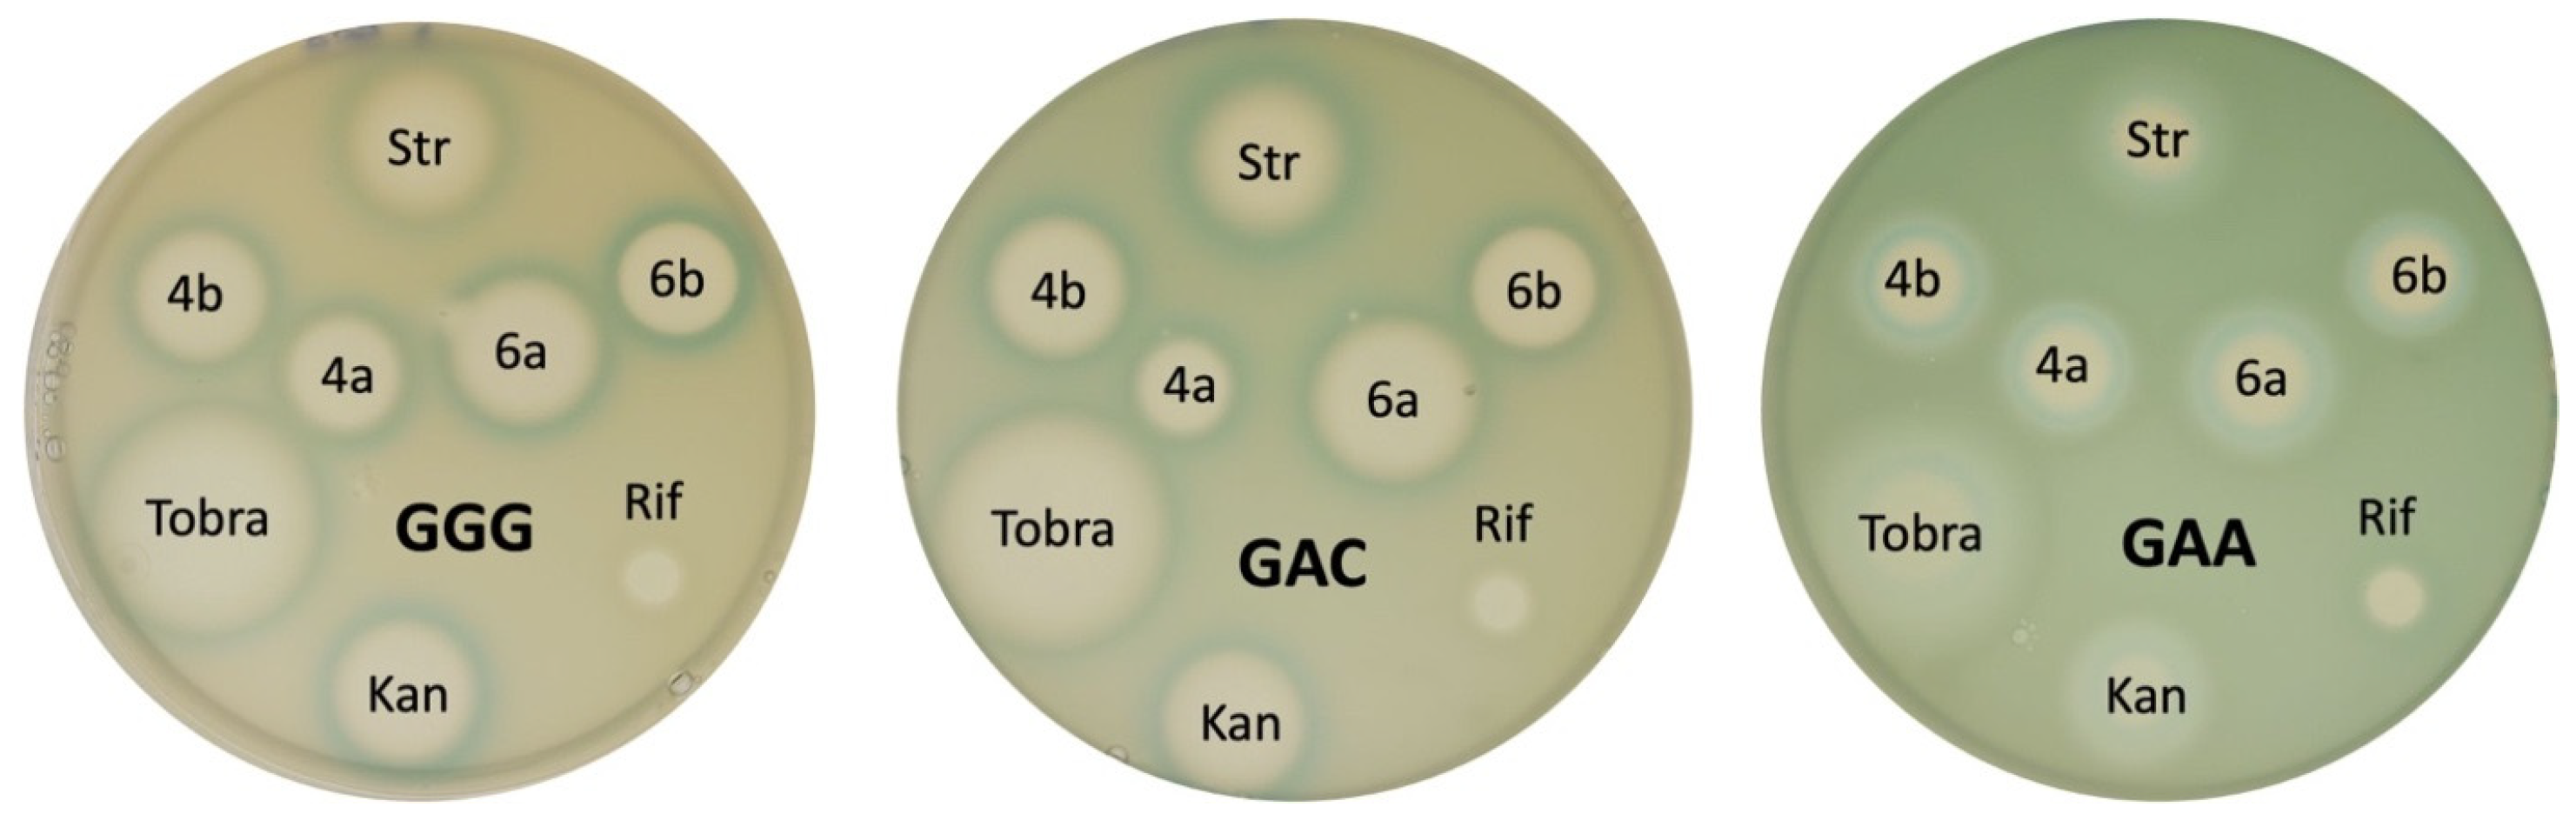
Antibiotics 13 01191 g004 Antibiotics 13 01191 g004

Synthesis and Antibacterial Activity of New 6″-Modified Tobramycin Derivatives
Abstract
1. Introduction
2. Results and Discussion
2.1. Chemistry
2.2. In Vitro Antibacterial Activity Studies
2.3. In Vitro Cytotoxicity Studies
2.4. Cell-Free Translation Inhibition Assay
2.5. Mechanism of Action
3. Materials and Methods
3.1. Chemistry
3.2. Microorganisms
3.3. Determination of the Minimum Inhibitory Concentration on E. coli Against Aminoglycoside-Resistant Mutants
3.4. MTT Assay
3.5. Cell-Free Translation Inhibition Assay
3.6. Determination of Translation Accuracy Using Reporters
4. Conclusions
Supplementary Materials
Author Contributions
Funding
Institutional Review Board Statement
Informed Consent Statement
Data Availability Statement
Acknowledgments
Conflicts of Interest
References
- Ferri, M.; Ranucci, E.; Romagnoli, P.; Giaccone, V. Antimicrobial Resistance: A Global Emerging Threat to Public Health Systems. Crit. Rev. Food Sci. Nutr. 2017, 57, 2857–2876. [Google Scholar] [CrossRef] [PubMed]
- Jesudason, T. WHO publishes updated list of bacterial priority pathogens. Lancet Microbe 2024, 5, 100940. [Google Scholar] [CrossRef] [PubMed]
- O’Neill, J. Tackling Drug-Resistant Infections Globally: Final Report and Recommendations. In Review on Antimicrobial Resistance; Wellcome Trust: London, UK, 2016; pp. 1–84. [Google Scholar]
- Menzies, D.; Benedetti, A.; Paydar, A.; Martin, I.; Royce, S.; Pai, M.; Vernon, A.; Lienhardt, C.; Burman, W. Effect of Duration and Intermittency of Rifampin on Tuberculosis Treatment Outcomes: A Systematic Review and Meta-analysis. PLoS Med. 2009, 6, e1000146. [Google Scholar] [CrossRef] [PubMed]
- Takhtamysheva, A.V. Treatment with Inhaled Antibiotics as One of the Measures to Combat Bacterial Resistance (Cystic Fibrosis is Used as an Example). Tuberc. Lung Dis. 2024, 102, 82–86. (In Russian) [Google Scholar] [CrossRef]
- Bassetti, M.; Vena, A.; Croxatto, A.; Righi, E.; Guery, B. How to manage Pseudomonas aeruginosa infections. Drugs Context 2018, 7, 212527. [Google Scholar] [CrossRef]
- De Oliveira, D.M.; Forde, B.M.; Kidd, T.J.; Harris, P.N.A.; Schembri, M.A.; Beatson, S.A.; Paterson, D.L.; Walkeret, M.J. Antimicrobial resistance in ESKAPE pathogens. Clin. Microbiol. Rev. 2020, 33, e00181-19. [Google Scholar] [CrossRef]
- Thacharodi, A.; Lamont, I.L. Gene–gene interactions reduce aminoglycoside susceptibility of Pseudomonas aeruginosa through efflux pump-dependent and-independent mechanisms. Antibiotics 2023, 12, 152. [Google Scholar] [CrossRef]
- Selimoglu, E. Aminoglycoside-Induced Ototoxicity. Curr. Pharm. Des. 2007, 13, 119–126. [Google Scholar] [CrossRef]
- Lopez-Novoa, J.M.; Quiros, Y.; Vicente, L.; Morales, A.I.; Lopez-Hernandez, F.J. New Insights into the Mechanism of Aminoglycoside Nephrotoxicity: An Integrative Point of View. Kidney Int. 2011, 79, 33–45. [Google Scholar] [CrossRef]
- Krause, K.M.; Serio, A.W.; Kane, T.R.; Connolly, L.E. Aminoglycosides: An Overview. Cold Spring Harb. Perspect. Med. 2016, 6, a027029. [Google Scholar] [CrossRef]
- Al-Tawfiq, J.A.; Momattin, H.; Al-Ali, A.Y.; Eljaaly, K.; Tirupathi, R.; Haradwala, M.B.; Areti, S.; Alhumaid, S.; Rabaan, A.A.; Mutair, A.A.; et al. Antibiotics in the Pipeline: A Literature Review (2017–2020). Infection 2021, 50, 553–564. [Google Scholar] [CrossRef] [PubMed]
- Tevyashova, A.N.; Shapovalova, K.S. Potential for the Development of a New Generation of Aminoglycoside Antibiotics. Pharm. Chem. J. 2021, 55, 860–875. [Google Scholar] [CrossRef]
- Chandrika, N.T.; Garneau-Tsodikova, S. Comprehensive Review of Chemical Strategies for the Preparation of New Aminoglycosides and Their Biological Activities. Chem. Soc. Rev. 2018, 47, 1189–1249. [Google Scholar] [CrossRef]
- Dhondikubeer, R.; Bera, S.; Zhanel, G.G.; Schweizer, F. Antibacterial activity of amphiphilic tobramycin. J. Antibiot. 2012, 65, 495–498. [Google Scholar] [CrossRef]
- Berkov-Zrihen, Y.; Herzog, I.M.; Benhamou, R.I.; Feldman, M.; Steinbuch, K.B.; Shaul, P.; Lerer, S.; Eldar, A.; Fridman, M. Tobramycin and nebramine as pseudo-oligosaccharide scaffolds for the development of antimicrobial cationic amphiphiles. Chemistry 2015, 21, 4340–4349. [Google Scholar] [CrossRef]
- Herzog, I.M.; Green, K.D.; Berkov-Zrihen, Y.; Feldman, M.; Vidavski, R.R.; Eldar-Boock, A.; Satchi-Fainaro, R.; Eldar, A.; Garneau-Tsodikova, S.; Fridman, M. 6″-thioether tobramycin analogues: Towards selective targeting of bacterial membranes. Angew. Chem. 2012, 51, 5652–5656. [Google Scholar] [CrossRef]
- Guchhait, G.; Altieri, A.; Gorityala, B.; Yang, X.; Findlay, B.; Zhanel, G.G.; Mookherjee, N.; Schweizer, F. Amphiphilic tobramycins with immunomodulatory properties. Angew. Chem. 2015, 54, 6278–8622. [Google Scholar] [CrossRef]
- Fosso, M.Y.; Zhu, H.; Green, K.D.; Garneau-Tsodikova, S.; Fredrick, K. Tobramycin variants with enhanced ribosome-targeting activity. ChemBioChem 2015, 16, 1565–1570. [Google Scholar] [CrossRef]
- Herzog, I.M.; Feldman, M.; Eldar-Boock, A.; Satchi-Fainaro, R.; Fridman, M. Design of membrane targeting tobramycin-based cationic amphiphiles with reduced hemolytic activity. MedChemComm 2013, 4, 120–124. [Google Scholar] [CrossRef]
- Fosso, M.Y.; Shrestha, S.K.; Green, K.D.; Garneau-Tsodikova, S. Synthesis and bioactivities of kanamycin B-derived cationic amphiphiles. J. Med. Chem. 2015, 58, 9124–9132. [Google Scholar] [CrossRef]
- Shrestha, S.K.; Fosso, M.Y.; Green, K.D.; Garneau-Tsodikova, S. Amphiphilic tobramycin analogues as antibacterial and antifungal agents. Antimicrob. Agents Chemother. 2015, 59, 4861–4869. [Google Scholar] [CrossRef] [PubMed]
- Fosso, M.Y.; Shrestha, S.K.; Thamban Chandrika, N.; Dennis, E.K.; Green, K.D.; Garneau-Tsodikova, S. Differential effects of linkers on the activity of amphiphilic tobramycin antifungals. Molecules 2018, 23, 899. [Google Scholar] [CrossRef] [PubMed]
- Tevyashova, A.; Efimova, S.; Alexandrov, A.; Omelchuk, O.; Ghazy, E.; Bychkova, E.; Zatonsky, G.; Grammatikova, N.; Dezhenkova, L.; Solovieva, S.; et al. Semisynthetic amides of amphotericin B and nystatin A1: A comparative study of in vitro activity/toxicity ratio in relation to selectivity to ergosterol membranes. Antibiotics 2023, 12, 151. [Google Scholar] [CrossRef]
- Moiseenko, E.I.; Erdei, R.; Grammatikova, N.E.; Mirchink, E.P.; Isakova, E.B.; Pereverzeva, E.R.; Batta, G.; Shchekotikhin, A.E. Aminoalkylamides of eremomycin exhibit an improved antibacterial activity. Pharmaceuticals 2021, 14, 379. [Google Scholar] [CrossRef]
- Sergeev, A.V.; Tevyashova, A.N.; Vorobyov, A.P.; Gromova, E.S. The Effect of Antitumor Antibiotic Olivomycin A and Its New Semi-synthetic Derivative Olivamide on the Activity of Murine DNA Methyltransferase Dnmt3a. Biochem. Mosc. 2019, 84, 62–70. [Google Scholar] [CrossRef] [PubMed]
- Ramirez, D.M.; Ramirez, D.; Dhiman, S.; Arora, R.; Lozeau, C.; Arthur, G.; Zhanel, G.; Schweizer, F. Guanidinylated Amphiphilic Tobramycin Derivatives Synergize with β-Lactam/β-Lactamase Inhibitor Combinations against Pseudomonas aeruginosa. ACS Infect Dis. 2023, 9, 1754–1768. [Google Scholar] [CrossRef]
- Tikhomirov, A.S.; Abdelhamid, M.A.; Nadysev, G.Y.; Zatonsky, G.V.; Bykov, E.E.; Chueh, P.J.; Waller, Z.A.E.; Shchekotikhin, A.E. Water-soluble heliomycin derivatives to target i-Motif DNA. J. Nat. Prod. 2021, 84, 1617–1625. [Google Scholar] [CrossRef]
- Shapovalova, K.; Zatonsky, G.; Grammatikova, N.; Osterman, I.; Razumova, E.; Shchekotikhin, A.; Tevyashova, A. Synthesis of 6″-Modified Kanamycin A Derivatives and Evaluation of Their Antibacterial Properties. Pharmaceutics 2023, 15, 1177. [Google Scholar] [CrossRef] [PubMed]
- Hadidi, K.; Wexselblatt, E.; Esko, J.D.; Tor, Y. Cellular uptake of modified aminoglycosides. J. Antibiot. 2018, 71, 142–145. [Google Scholar] [CrossRef]
- Mogre, A.; Sengupta, T.; Veetil, R.T.; Ravi, P.; Seshasayee, A.S.N. Genomic analysis reveals distinct concentration-dependent evolutionary trajectories for antibiotic resistance in Escherichia coli. DNA Res. 2014, 21, 711–726. [Google Scholar] [CrossRef]
- Mogre, A.; Veetil, R.T.; Seshasayee, A.S.N. Modulation of global transcriptional regulatory networks as a strategy for increasing kanamycin resistance of the translational elongation factor-G mutants in Escherichia coli. G3 Genes Genomes Genet. 2017, 7, 3955–3966. [Google Scholar] [CrossRef] [PubMed]
- Mosmann, T. Rapid colorimetric assay for cellular growth and survival: Application to proliferation and cytotoxicity assays. J. Immunol. Methods 1983, 65, 55–63. [Google Scholar] [CrossRef] [PubMed]
- Baba, T.; Ara, T.; Hasegawa, M.; Takai, Y.; Okumura, Y.; Baba, M.; Mori, H. Construction of Escherichia coli K-12 in frame, single gene knockout mutants: The Keio collection. Mol. Syst. Biol. 2006, 2, 2006.0008. [Google Scholar] [CrossRef] [PubMed]
- Jospe-Kaufman, M.; Siomin, L.; Fridman, M. The relationship between the structure and toxicity of aminoglycoside antibiotics. Bioorg. Med. Chem. Lett. 2020, 30, 127218. [Google Scholar] [CrossRef] [PubMed]
- Manickam, N.; Nag, N.; Abbasi, A.; Patel, K.; Farabaugh, P.J. Studies of translational misreading in vivo show that the ribosome very efficiently discriminates against most potential errors. RNA 2014, 20, 9–15. [Google Scholar] [CrossRef]
- Michael, K.; Wang, H.; Tor, Y. Enhanced RNA binding of dimerized aminoglycosides. Bioorg. Med. Chem. 1999, 7, 1361–1371. [Google Scholar] [CrossRef]
- M07-A10; Methods for Dilution Antimicrobial Susceptibility Tests for Bacteria That Grow Aerobically. Approved Standard, 10th ed. Clinical and Laboratory Standards Institute (CLSI): Wayne, PA, USA, 2015.
- Datsenko, K.A.; Wanner, B.L. One-Step Inactivation of Chromosomal Genes in Escherichia Coli K-12 Using PCR Products. Proc. Natl. Acad. Sci. USA 2000, 97, 6640–6645. [Google Scholar] [CrossRef]
- Lukianov, D.A.; Buev, V.S.; Ivanenkov, Y.A.; Kartsev, V.G.; Skvortsov, D.A.; Osterman, I.A.; Sergiev, P.V. Imidazole Derivative As a Novel Translation Inhibitor. Acta Nat. 2022, 14, 71. [Google Scholar] [CrossRef]

![]() | ||||||
|---|---|---|---|---|---|---|
| Compound | R | MIC *, µg/mL | ||||
| S. aureus ATCC 29213 | E. coli ATCC 25922 | E. coli JW5503 | P. aeruginosa ATCC 27853 | M. smegmatis ATCC 607 | ||
| Tobramycin | OH | 0.06 | 0.25 | 1 | 0.5 | 0.06 |
| 4a | ![]() | 0.125 | 0.5 | 2 | 1 | 0.125 |
| 4b | ![]() | 0.125 | 1 | 8 | 8 | 0.125 |
| 6a | ![]() | 0.125 | 1 | 4 | 1 | 0.125 |
| 6b | ![]() | 0.5 | 2 | 8 | 2 | 0.25 |
| Kanamycin A | OH | 0.5 | 1 | 1 | >32 | 0.125 |
| 7 | ![]() | 0.125 | 1 | 4 | >32 | 0.06 |
![]() | |||||||
|---|---|---|---|---|---|---|---|
| Compound | R | MIC, µg/mL | |||||
| P. aeruginosa Strains | |||||||
| ATCC 27853 | 27853 | 27853 | 27853 | 27853 | 27853 | ||
| Tobramycin | OH | 0.5 | >128 | >128 | >128 | >32 | >32 |
| Ciprofloxacin | - | 0.125 | 32 | 64 | 32 | 32 | 32 |
| Aztreonam | - | 4 | 16 | 8 | 32 | 16 | 16 |
| 4a | ![]() | 1 | 16 | 32 | >32 | >32 | 32 |
| 4b | ![]() | 8 | 32 | 32 | >32 | >32 | >32 |
| 6a | ![]() | 1 | 16 | 16 | >32 | 32 | 32 |
| 6b | ![]() | 2 | 16 | 32 | >32 | >32 | >32 |
| 7 | ![]() | >128 | >128 | >128 | >128 | >128 | >128 |
![]() | ||||
|---|---|---|---|---|
| Compound | R | MIC, µg/mL | ||
| E. coli JW5503 kanS [34] | E. coli JW5503 kanS EF-G P610T | E. coli JW5503 kanS EF-G P610L | ||
| Tobramycin | OH | 5 | 20 | 40 |
| 4a | ![]() | 10 | 40 | 40 |
| 4b | ![]() | 20 | 80 | 80 |
| 6a | ![]() | 10 | 40 | 40 |
| 6b | ![]() | 40 | 80 | 80 |
| Kanamycin A | - | 5 | 80 | 80 |
| Rifampicin | - | 5 | 5 | 5 |
| Erythromycin | - | 2 | 2 | 2 |
| Compound | IC50, µg/mL |
|---|---|
| 4a | >140 |
| 4b | >140 |
| 6a | >140 |
| 6b | >140 |
| Tobramycin | 58 ± 3 |
Disclaimer/Publisher’s Note: The statements, opinions and data contained in all publications are solely those of the individual author(s) and contributor(s) and not of MDPI and/or the editor(s). MDPI and/or the editor(s) disclaim responsibility for any injury to people or property resulting from any ideas, methods, instructions or products referred to in the content. |
© 2024 by the authors. Licensee MDPI, Basel, Switzerland. This article is an open access article distributed under the terms and conditions of the Creative Commons Attribution (CC BY) license (https://creativecommons.org/licenses/by/4.0/).
Share and Cite
Shapovalova, K.S.; Zatonsky, G.V.; Razumova, E.A.; Ipatova, D.A.; Lukianov, D.A.; Sergiev, P.V.; Grammatikova, N.E.; Tikhomirov, A.S.; Shchekotikhin, A.E. Synthesis and Antibacterial Activity of New 6″-Modified Tobramycin Derivatives. Antibiotics 2024, 13, 1191. https://doi.org/10.3390/antibiotics13121191
Shapovalova KS, Zatonsky GV, Razumova EA, Ipatova DA, Lukianov DA, Sergiev PV, Grammatikova NE, Tikhomirov AS, Shchekotikhin AE. Synthesis and Antibacterial Activity of New 6″-Modified Tobramycin Derivatives. Antibiotics. 2024; 13(12):1191. https://doi.org/10.3390/antibiotics13121191
Chicago/Turabian StyleShapovalova, Kseniya S., Georgy V. Zatonsky, Elizaveta A. Razumova, Daria A. Ipatova, Dmitrii A. Lukianov, Petr V. Sergiev, Natalia E. Grammatikova, Alexander S. Tikhomirov, and Andrey E. Shchekotikhin. 2024. "Synthesis and Antibacterial Activity of New 6″-Modified Tobramycin Derivatives" Antibiotics 13, no. 12: 1191. https://doi.org/10.3390/antibiotics13121191
APA StyleShapovalova, K. S., Zatonsky, G. V., Razumova, E. A., Ipatova, D. A., Lukianov, D. A., Sergiev, P. V., Grammatikova, N. E., Tikhomirov, A. S., & Shchekotikhin, A. E. (2024). Synthesis and Antibacterial Activity of New 6″-Modified Tobramycin Derivatives. Antibiotics, 13(12), 1191. https://doi.org/10.3390/antibiotics13121191


















